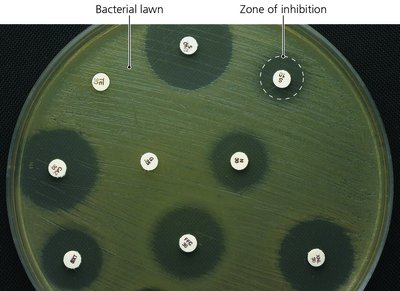
Kirby-Bauer test showing zones of inhibition
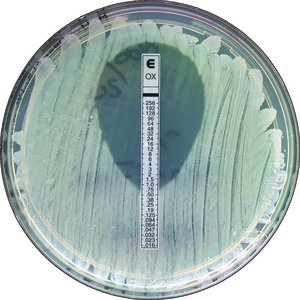
Etest for determining MIC

Back
BackControlling Microbial Growth in the Body: Antimicrobial Drugs (Chapter 10, Part B)
Study Guide - Smart Notes

Controlling Microbial Growth in the Body: Antimicrobial Drugs
Ideal Characteristics of Antimicrobial Agents
Antimicrobial agents are substances used to kill or inhibit the growth of microorganisms within the body. The ideal agent should possess several key characteristics to maximize efficacy and minimize harm to the patient.
Readily available: The drug should be easy to obtain and distribute.
Inexpensive: Cost-effectiveness is crucial for widespread use.
Chemically stable: Stability ensures the drug remains effective during storage and use.
Easily administered: Simple administration increases patient compliance.
Nontoxic and nonallergenic: The drug should not cause significant toxicity or allergic reactions.
Selectively toxic: The agent should target a wide range of pathogens without harming the host.
Clinical Considerations in Prescribing Antimicrobial Drugs
When selecting an antimicrobial drug, clinicians must consider the drug's spectrum of activity, efficacy, route of administration, and potential side effects.
Spectrum of Activity
The spectrum of an antimicrobial refers to the range of microorganisms it is effective against. Drugs may be narrow-spectrum (targeting specific groups) or broad-spectrum (effective against a wide variety of organisms).

Diffusion Susceptibility (Kirby-Bauer) Test
This test evaluates the effectiveness of antibiotics against specific bacteria by measuring the zone of inhibition around antibiotic-impregnated disks on an agar plate. Larger zones indicate greater susceptibility.
Minimum Inhibitory Concentration (MIC) Test
The MIC test determines the lowest concentration of an antimicrobial that inhibits visible growth of a microorganism. This is essential for determining the appropriate dosage for treatment.

Etest
The Etest combines aspects of the MIC and Kirby-Bauer tests, using a strip with a gradient of antibiotic concentrations to determine the MIC directly on an agar plate.
Minimum Bactericidal Concentration (MBC) Test
The MBC test identifies the lowest concentration of an antimicrobial that kills 99.9% of the original inoculum. It is used to distinguish between bacteriostatic and bactericidal agents.

Routes of Administration
The method of drug administration affects the concentration of the drug in the bloodstream and its distribution to infected tissues. Common routes include:
Topical: Applied directly to external infections.
Oral: Taken by mouth; convenient and self-administered.
Intramuscular (IM): Injected into muscle tissue.
Intravenous (IV): Delivered directly into the bloodstream for rapid and high concentrations.

Safety and Side Effects
Antimicrobial drugs can cause adverse effects, including:
Toxicity: Some drugs may be toxic to organs such as the kidneys, liver, or nerves. Special caution is needed for pregnant women.
Allergies: Allergic reactions, though rare, can be severe (e.g., anaphylactic shock).
Disruption of normal microbiota: Broad-spectrum antibiotics can disrupt the balance of normal flora, leading to secondary infections or overgrowth of opportunistic pathogens.

Therapeutic Index
The therapeutic index (TI) is the ratio of the toxic dose to the effective dose of a drug. A higher TI indicates a safer drug.
Formula:

Clinical Susceptibility Data Example
Antimicrobial susceptibility testing helps guide therapy. For example, Pseudomonas aeruginosa may be classified as sensitive, intermediate, or resistant to various drugs based on MIC values. Considerations include potential toxicity and spectrum of activity.
Drug | MIC (mcg/ml) | Classification | Considerations |
|---|---|---|---|
Amikacin | 8 | Sensitive | Potential renal toxicity (aminoglycoside) |
Cefepime | 16 | Sensitive | Cephalosporin, broad spectrum |
Ciprofloxacin | >4 | Resistant | |
Levofloxacin | >4 | Resistant | |
Gentamicin | 8 | Intermediate | |
Ceftazidime | 4 | Sensitive | Combination cephalosporin – beta-lactamase inhibitor, broad spectrum, active against Gram-negative bacteria |
Antibiotic Resistance
Threat Levels Defined by CDC
The Centers for Disease Control and Prevention (CDC) classifies microbial resistance threats as:
Urgent: High potential for widespread, life-threatening disease.
Serious: Alternative antimicrobials are available or disease incidence is low/declining.
Concerning: Low threat or many antimicrobials are available for treatment.
Development of Resistance
Some pathogens are naturally resistant, while others acquire resistance through:
New mutations in chromosomal genes.
Acquisition of R plasmids via horizontal gene transfer mechanisms:
Transformation: Uptake of free DNA from the environment.
Transduction: Transfer of DNA by bacteriophages.
Conjugation: Direct transfer of DNA between bacteria.

Mechanisms of Antibiotic Resistance
Bacteria employ several mechanisms to resist antibiotics:
Altered porin proteins: Reduce drug uptake (e.g., beta-lactams, aminoglycosides).
Efflux pumps: Actively expel drugs from the cell (e.g., tetracyclines, quinolones, macrolides).
Altered targets: Modify drug binding sites (affects many drug classes).
Enzyme deactivation: Enzymes such as beta-lactamases inactivate drugs (e.g., beta-lactams, aminoglycosides, macrolides).


Beta-Lactam Antibiotic Resistance
Resistance to beta-lactam antibiotics (e.g., penicillins, cephalosporins) can occur by:
Lowering the affinity of target enzymes for the drug.
Producing beta-lactamase enzymes that degrade the antibiotic.
Altering porin proteins to prevent drug entry.

Spread of Resistance in Bacterial Populations
Resistance genes spread primarily through horizontal gene transfer, not by drug-induced mutations. Mechanisms include transformation, transduction, and conjugation.
Efflux Pumps and Multidrug Resistance
Some bacteria are resistant to multiple antimicrobials because they possess efflux pumps that actively expel drugs from the cell, reducing intracellular drug concentration and efficacy.

Therapeutic Window
The therapeutic window is the range of drug concentrations that are both effective and non-toxic. It is critical to maintain drug levels within this window to maximize efficacy and minimize harm.
Formula:
Additional info: These notes are based on standard microbiology curriculum and expanded with academic context for clarity and completeness.
